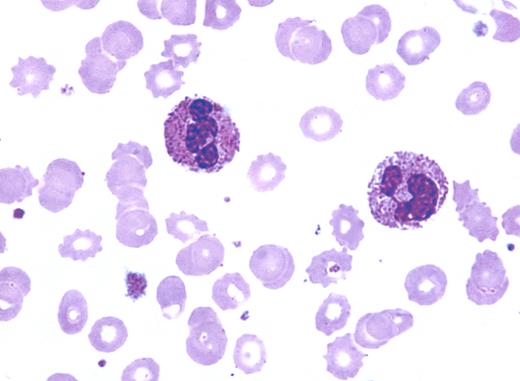
A 28-year-old woman was seen for lethargy by her primary care physician. A complete blood count was obtained, and the report indicted mild anemia and toxic granulation of neutrophils. Although she was afebrile, a course of antibiotics was given but without any benefit. A referral for mild anemia was made to a hematologist. / Her medical history included normal menses, no other blood loss, and 2 previous uncomplicated pregnancies. The family history was unremarkable. The peripheral smear was reviewed (see figure), and toxic granulation was affirmed. However, “burr”-shaped red cells were also seen. / Toxic granulation can be associated with infection and inflammation. Increased granulation of neutrophils may also be present in some genetic disorders, following treatment with myeloid growth factors (G-CSF or GM-CSF), in a marrow responding to myelosuppressive therapy, with pregnancy, and in uremia. The combination of disfigured red cells and toxic granulation raised the possibility of renal failure. Additional laboratory work affirmed azotemia, accompanied by mildly elevated phosphorus and lowered calcium.

A 28-year-old woman was seen for lethargy by her primary care physician. A complete blood count was obtained, and the report indicted mild anemia and toxic granulation of neutrophils. Although she was afebrile, a course of antibiotics was given but without any benefit. A referral for mild anemia was made to a hematologist.
Her medical history included normal menses, no other blood loss, and 2 previous uncomplicated pregnancies. The family history was unremarkable. The peripheral smear was reviewed (see figure), and toxic granulation was affirmed. However, “burr”-shaped red cells were also seen.
Toxic granulation can be associated with infection and inflammation. Increased granulation of neutrophils may also be present in some genetic disorders, following treatment with myeloid growth factors (G-CSF or GM-CSF), in a marrow responding to myelosuppressive therapy, with pregnancy, and in uremia. The combination of disfigured red cells and toxic granulation raised the possibility of renal failure. Additional laboratory work affirmed azotemia, accompanied by mildly elevated phosphorus and lowered calcium.
A 28-year-old woman was seen for lethargy by her primary care physician. A complete blood count was obtained, and the report indicted mild anemia and toxic granulation of neutrophils. Although she was afebrile, a course of antibiotics was given but without any benefit. A referral for mild anemia was made to a hematologist.
Her medical history included normal menses, no other blood loss, and 2 previous uncomplicated pregnancies. The family history was unremarkable. The peripheral smear was reviewed (see figure), and toxic granulation was affirmed. However, “burr”-shaped red cells were also seen.
Toxic granulation can be associated with infection and inflammation. Increased granulation of neutrophils may also be present in some genetic disorders, following treatment with myeloid growth factors (G-CSF or GM-CSF), in a marrow responding to myelosuppressive therapy, with pregnancy, and in uremia. The combination of disfigured red cells and toxic granulation raised the possibility of renal failure. Additional laboratory work affirmed azotemia, accompanied by mildly elevated phosphorus and lowered calcium.
Many Blood Work images are provided by the ASH IMAGE BANK, a reference and teaching tool that is continually updated with new atlas images and images of case studies. For more information or to contribute to the Image Bank, visit www.ashimagebank.org.
This feature is available to Subscribers Only
Sign In or Create an Account Close Modal